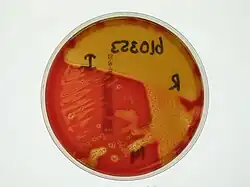

Glomerulonefritis posestreptocócica
| Glomerulonefritis posestreptocócica | ||
|---|---|---|
![]() | ||
| Especialidad | nefrología | |
| Sinónimos | ||
| Glomerulonefritis proliferativa aguda, glomerulonefritis posinfecciosa | ||
La glomerulonefritis posestreptocócica, también conocida como glomerulonefritis proliferativa aguda o glomerulonefritis posinfecciosa, es una enfermedad inflamatoria de los glomérulos (glomerulonefritis), o sea los pequeños vasos capilares en forma de ovillo encargados de la ultrafiltración renal, que aparece como una complicación común de las infecciones causadas por bacterias del género Streptococcus, típicamente el impétigo y la faringitis estreptocócica.[1][2] Es uno de los principales factores de riesgo de desarrollar albuminuria y es el síndrome nefrítico prototípico.[3]
Historia
En 1792, durante una epidemia de escarlatina, Plenciz[4] observó que algunos pacientes afectados también presentaban síntomas urinarios (hematuria, edema y oliguria). Más adelante, en el siglo XIX, Richard Bright publicó el primer estudio morfológico en pacientes con glomerulonefritis posinfecciosa[5] y en 1929 Longcope describió la asociación entre la glomerulonefritis aguda y la infección de las vías respiratorias altas por estreptococos betahemolíticos.[6][7]
Hace más de noventa años Bela Schick (1877-1967) destacó la patogenia “alérgica” de la glomerulonefritis al observar semejanzas entre la nefritis producida en la convalecencia de la escarlatina y el período de latencia de la enfermedad aguda del suero.[8] Clemens Freiherr von Pirquet, un pediatra que inició su trabajo de investigación con Bela Schick en 1903, cuando tenía solo 29 años,[9] describió la glomerulonefritis posestreptocócica en 1911, después de la observación de Wells, que en 1812 la había descrito como una complicación posterior a la convalecencia de la escarlatina.[10] En 1912, sobre la base de sus investigaciones, Schick opinó que la glomerulonefritis aguda podría ser resultado de una reacción inmune a una infección bacteriana más que el producto de una agresión bacteriana directa, concepto que durante muchos años fue considerado con cierto escepticismo pero que hoy se encuentra en la situación opuesta.[11]
Luego, en 1941, Seegal y Earle propusieron la existencia de cepas nefritogénas (asociadas con glomerulonefritis) que hoy se sabe que son cepas de estreptococos betahemolíticos del grupo A,[12] en particular de los tipos 1, 2, 4 y 12 en el caso de las infecciones faríngeas y 49, 55, 57 y 60 en el de las cutáneas. Es importante recordar que mientras que la fiebre reumática puede ser resultado de la infección por cualquier tipo de estreptococo del grupo A y presentar múltiples recaídas, en la glomerulonefritis aguda posestreptocócica tratada a tiempo las recaídas prácticamente no existen.[13]
En 1953 Rammelkamp y Weaver[12] y ese mismo año Wertheim y col. demostraron la existencia de una relación entre la glomerulonefritis aguda y las infecciones causadas por cepas de estreptococo betahemolítico de tipo 12.[14] Por último, en un estudio más reciente (de 1983) se informaba que la infección por Streptococcus betahemolítico del grupo C puede evolucionar a complicaciones graves entre las cuales se mencionaba la glomerulonefritis.[15]
Epidemiología
Si bien no es posible establecer la incidencia exacta de la glomerulonefritis aguda posinfecciosa a causa de la existencia de formas clínicas asintomáticas, se sabe que en los países desarrollados esa incidencia ha disminuido de manera considerable en los últimos treinta años gracias a las mejoras logradas en las condiciones higiénicas, a la amplia utilización de antibióticos, al reconocimiento temprano de la enfermedad, a la modificación del potencial nefritógeno de las cepas de estreptococo y al posible aumento de la resistencia natural del huésped.[16] La glomerulonefritis aguda posestreptocócica sigue siendo la causa más común de síndrome nefrítico en niños: se estima que en el mundo hay 470.000 casos nuevos al año y que el noventa y siete por ciento de esos casos corresponden a países en vías de desarrollo. La enfermedad es más frecuente en niños de entre cuatro y catorce años y es rara en menores de dos (menos del cinco por ciento de los casos) y en mayores de veinte. Por razones que se desconocen su frecuencia es dos veces más elevada en varones que en mujeres.[16]
Las infecciones faríngeas son causadas por los serotipos nefritógenos del estreptococo betahemolítico del grupo A (SBHGA) 1, 2, 4, 12 y 25 en tanto que en las infecciones cutáneas intervienen los serotipos 2, 42, 49, 56, 57 y 60.[16] La distribución típica de los casos de glomerulonefritis aguda posestreptocócica es estacional: las formas secundarias a infecciones rinofaríngeas predominan en invierno y las secundarias a infecciones cutáneas lo hacen en verano. La enfermedad se presenta en forma de casos esporádicos y epidémicos. Los casos esporádicos suelen observarse después de una infección faríngea vinculada con SBHGA de tipo 12 mientras que los epidémicos en general se deben a cepas de SBHGA productoras de infecciones faríngeas o cutáneas. El período de latencia de las formas posestreptocócicas es más prolongado tras las infecciones cutáneas (tres-cinco semanas) que después de las infecciones de las vías respiratorias superiores (siete-quince días). Las formas no estreptocócicas son esporádicas y la nefropatía coexiste con el proceso infeccioso.[16]
Etiología
La glomerulonefritis aguda posestreptocócica es el paradigma de las glomerulonefritis agudas posinfecciosas y su presentación clínica más característica es el síndrome nefrítico.[16]
Casi todas las glomerulonefritis agudas posinfecciosas son causadas por estreptococos pero existen muchos otros agentes patógenos que pueden producirlas (en especial bacterias y en menor medida virus, parásitos y hongos).[nota 1][nota 2][nota 3]
Entre las bacterias que causan esta enfermedad figuran, en orden de frecuencia:
Estreptococos betahemolíticos del grupo A (SBHGA), estafilococos, neumococos, Haemophilus influenzae, meningococos, Mycoplasma, Salmonella typhi, Pseudomonas y Treponema pallidum.
Los virus asociados con glomerulonefritis aguda posinfecciosa son los siguientes:[nota 4]
Virus de Epstein-Barr, citomegalovirus, Coxsackievirus, virus de la hepatitis B, virus de la hepatitis C, virus de la parotiditis, virus del sarampión, virus de la varicela, parvovirus B19, virus de la rubéola y virus de la inmunodeficiencia humana o HIV.
Los parásitos incluyen:
Plasmodium falciparum, Toxoplasma gondii, filarias, Schistosoma mansoni, Leishmania y Echinococcus granulosus.[21]
Y entre los hongos están:
Candida albicans y Coccidioides immitis.
Por último, entre las entidades infecciosas que pueden intervenir en la patogenia de la glomerulonefritis posinfecciosa figuran:
Amigdalitis aguda, infecciones nasofaríngeas e impétigo (las más frecuentes), neumonía y bronconeumonía, endocarditis bacteriana, infección de un shunt ventriculoauricular o ventriculoperitoneal, abscesos viscerales, fiebre tifoidea, brucelosis, hepatitis B, sífilis congénita[16] y paludismo.[1][2]
Fisiopatología

La fisiopatología exacta sigue estando en duda pero se cree que es una reacción de hipersensibilidad de tipo 3. Los complejos inmunes (complejos antígeno-anticuerpo formados durante la infección) se depositan en la membrana basal debajo de los pedicelos de los podocitos. Esto crea una apariencia grumosa y llena de cavitaciones en la microscopia de luz y jorobas subepiteliales en la microscopia electrónica.[1]
Después, al existir demasiados complejos antígeno-anticuerpo en el mismo lugar, se activa el sistema de complemento, lo que lleva a la destrucción de la membrana basal. También se ha propuesto que los antígenos específicos de ciertas infecciones estreptocócicas tendrían alta afinidad por las proteínas de la membrana basal, lo que daría lugar a una respuesta mediada por anticuerpos particularmente grave y crónica.[1]
La glomerulonefritis posestreptocócica es un síndrome nefrítico de modo que causa edema por aumento de la presión hidrostática y sobrecarga de líquido secundaria a daño inflamatorio. El daño renal provoca proteinuria, lo que ocasiona edema, precedido de hipertensión arterial en el síndrome nefrítico (caracterizado por proteinuria-menor de 3,5 g/día). El daño renal que podría observarse en una biopsia consistiría en necrosis renal aguda debida a una lesión por trombosis capilar.
Anatomía patológica
La glomerulonefritis posestreptocócica (que como ya se dijo también se llama glomerulonefritis aguda posinfecciosa, glomerulonefritis proliferativa endocapilar aguda y glomerulonefritis proliferativa exudativa) es un proceso clínico agudo que en los estudios de anatomía patológica se caracteriza por la presencia de depósitos electrodensos gruesos y numerosos localizados en la vertiente epitelial de la membrana basal glomerular. Esos depósitos tienen forma de “jorobas” (humps) y están constituidos por inmunocomplejos. Es posible que además de en la vertiente epitelial de la membrana haya depósitos en otros sitios, como por ejemplo depósitos subendoteliales, intramembranosos y mesangiales.[22]
Con la técnica de inmunofluorescencia pueden hallarse varios patrones de imágenes, los más comunes de los cuales son en guirnalda, en cielo estrellado y mesangial. El patrón mesangial por lo general corresponde a la fase de curación de la enfermedad y se caracteriza por escasez de depósitos en el mesangio. El patrón en cielo estrellado se debe a la presencia de depósitos pequeños, tanto en la pared capilar como a nivel mesangial. El patrón en guirnalda, que se ve con más frecuencia en varones y en pacientes con proteinuria importante y puede ser indicativo de una evolución más crónica y un pronóstico peor en el largo plazo, se observa en la cuarta parte de las biopsias renales y se caracteriza por un depósito subepitelial denso y prominente de inmunoglobulinas y de complemento, que confluye en áreas; los depósitos subendoteliales, los intramembranosos y los mesangiales son menos prominentes.[22] El patrón en guirnalda suele conferir un aspecto lobular al glomérulo, aunque en ocasiones puede asociarse con una lesión membranosa (a veces es difícil diferenciar el patrón en guirnalda de una lesión de la membrana).[23] En este patrón los depósitos subepiteliales tienden a ser más irregulares, de tamaño más desigual, de distribución discontinua en la luz y relacionados con un pronóstico más desfavorable.
Sobre la pared de los capilares y en el mesangio se encuentran depósitos granulares de C3 junto con IgG (las ya mencionadas “jorobas” o humps); también es posible hallar IgM, IgA, fibrina y otros componentes del complemento.[16] Salvo en caso de complicaciones y asociación con un componente proliferativo extracapilar la membrana basal en general es normal, tanto en grosor como en contorno.[22]
En la microscopia óptica la presentación típica es la de una glomerulonefritis proliferativa endocapilar caracterizada por proliferación celular difusa con aumento del número de células endoteliales y, en menor grado, de células mesangiales, acompañadas de infiltrado de la luz capilar y del mesangio por polimorfonucleares, monocitos y eosinófilos. La membrana basal glomerular es normal. El grado de oclusión de los capilares se correlaciona con el descenso del índice de filtración glomerular (IFG). En las formas más graves puede verse proliferación extracapilar con infiltrado celular en el espacio de Bowman y formación de semilunas epiteliales, lo que determina el desarrollo de una glomerulonefritis rápidamente progresiva. El daño glomerular y los signos clínicos están determinados por la localización de los inmunocomplejos. Las anomalías tubulares, intersticiales y vasculares en general son poco llamativas.[16]
En la microscopia electrónica la lesión más característica –aunque no patognomónica– de la glomerulonefritis aguda es la presencia en la vertiente externa de la membrana basal (subepitelial) de depósitos electrodensos informados como jorobas o humps. También puede haber depósitos subendoteliales, intramembranosos y mesangiales que son complejos inmunes y corresponden a los depósitos de IgG y C3 visualizados en la inmunofluorescencia.[16]
Cuadro clínico
La glomerulonefritis hace su presentación clínica de una a dos semanas después de una infección faríngea y hasta después de seis semanas de una infección cutánea por cepas de estreptococos betahemolíticos del grupo A, por una infección estafilocócica y hasta por una infección viral. El paciente o los familiares refieren la presencia de orina oscura y edema; además, se puede constatar hipertensión arterial, insuficiencia renal e insuficiencia cardíaca congestiva por sobrecarga de volumen. El exudado faríngeo y el de piel pueden ser positivos si aún no se ha instaurado un tratamiento antibiótico. Existe hipocomplementemia (C3, CH50) y el título de anticuerpos antiestreptolisina O (ASLO) se encuentra elevado. El cuadro clínico incluye hematuria, oliguria, edema nefrogénico, hipertensión y malestar general.[24]
La hematuria puede ser microscópica y es posible que no sea advertida a simple vista por el paciente. Cuando es macroscópica, la orina suele verse de color café oscuro y, si el cuadro es grave, será prácticamente sangre.
La oliguria, definida como un gasto urinario menor de 400 mL/día (el gasto normal es de 600 a 2.500 mL/día), en los niños se considera una diuresis menor de 0,5 mL/kg/h. Los pacientes suelen no notarla.
El edema, que es de aparición aguda y de gravedad leve a moderada, por lo general comienza en los párpados, luego se observa en los miembros inferiores y superiores y finalmente se generaliza. Puede desencadenar hidrocele, ascitis, derrame pericárdico y derrame pleural.
En cuanto a la hipertensión, usualmente es de leve a moderada y puede ocasionar —en casos graves— retinopatía hipertensiva, encefalopatía hipertensiva, insuficiencia cardíaca y edema pulmonar agudo.
El malestar general se debe a fiebre, dolor de cabeza, anorexia, náuseas, emesis (vómitos) y palidez, en general como consecuencia del edema o por anemia —secundaria a la posible hematuria—.
Diagnóstico
El diagnóstico es clínico y se basa en la exploración física y la anamnesis, en la que en general se registra alguna infección de este tipo. Rara vez se requiere una biopsia renal. Es posible que se detecten niveles séricos elevados de anticuerpos contra estreptococos y niveles de C3 y C4 bajos.[16]
La presencia de una glomerulonefritis aguda posinfecciosa debe sospecharse en un paciente con un cuadro clínico y bioquímico de síndrome nefrítico agudo: hematuria glomerular con proteinuria variable, edema con hipertensión arterial y oliguria con insuficiencia renal aguda. Como ya se dijo, suele existir el antecedente de una infección. Lo característico es que en las formas posestreptocócicas haya un período de latencia de una a dos semanas entre la infección y la nefritis posterior a una infección faríngea y uno de cuatro a seis semanas cuando la nefritis es secundaria a una infección cutánea. El período de latencia no existe en las formas no estreptocócicas, dado que en ellas la nefritis se desarrolla de manera simultánea con la infección.[16] Durante la anamnesis deben buscarse antecedentes familiares de enfermedades glomerulares que sugieran una glomerulopatía familiar (enfermedad de Alport, enfermedad de la membrana basal fina). Además de la historia clínica completa hay que realizar una exploración física minuciosa en busca de hallazgos sugestivos de enfermedad sistémica (púrpura, exantemas, artralgias, síntomas gastrointestinales, síntomas pulmonares, etcétera).[16]
Cuando el diagnóstico se retrasa porque hay pocos síntomas y microhematuria la enfermedad se detecta por el estudio familiar de un caso índice o en situaciones de epidemia. La posibilidad de glomerulopatía aguda posinfecciosa debe considerarse en todos los niños con manifestaciones clínicas secundarias a sobrecarga de volumen y la primera prueba diagnóstica debe ser el análisis de la orina.[16]
Como ya se dijo, el prototipo de las glomerulonefritis posinfecciosas es la glomerulonefritis aguda posestreptocócica y la presentación clínica más característica es el síndrome nefrítico agudo, aunque los casos subclínicos son muy numerosos. El descenso transitorio del C3 sérico es uno de los principales elementos diagnósticos. La biopsia en general se reserva para casos de curso clínico atípico.[16]
Los pacientes pueden excretar >0,5 a 2 g/m²/d de proteínas; el cociente proteínas/creatinina en orina puede ser <2 (el normal es de 0,1 a 0,3). En el sedimento urinario se reconocen eritrocitos dismórficos, leucocitos y células tubulares renales; es característico hallar cilindros con contenido de eritrocitos y hemoglobina (Hb) y son frecuentes los que contienen granulocitos y los cilindros granulosos.[25] La presencia simultánea de cilindros eritrocitarios, granulosos y hialinos es un elemento que apoya la sospecha de hematuria de origen glomerular.[26]
El título de anticuerpos contra el agente infeccioso causal suele aumentar en una a dos semanas. Se puede medir el incremento de los anticuerpos contra los productos antigénicos de los estreptococos: la detección de anticuerpos contra la antiestreptolisina O (ASLO) constituye el mejor indicador de infecciones de las vías respiratorias altas en tanto que el hallazgo de anticuerpos antihialuronidasa y antidesoxirribonucleasa B lo es del pioderma.[25] El nivel sérico de C3 y C4 suele ser bajo durante la fase activa de la enfermedad pero los niveles de complemento se normalizan en seis a ocho semanas en el 80 % de los casos de glomerulonefritis posestreptocócica (lo que no sucede en casi ningún caso de glomerulonefritis membranoproliferativa). La crioglobulinemia en general persiste durante varios meses, a diferencia de los complejos inmunes circulantes, que después de algunas semanas ya no se pueden detectar.[25]
Los cambios inflamatorios intersticiales suelen alterar la función tubular con la consiguiente reducción de la capacidad de concentración urinaria y excreción de ácido. Sin embargo, gracias a la capacidad glomerular intrínseca de hipertrofia esos defectos de la función tubular por lo general se observan antes de que se produzca una reducción importante del índice de filtración glomerular (IFG). Por último, con el progreso de las alteraciones glomerulares la superficie total de filtración se reduce de manera importante con el consiguiente descenso del IFG y el desarrollo de azoemia. El IFG se calcula a partir de la concentración de creatinina sérica o de la depuración urinaria de creatinina. Este índice suele normalizarse en un plazo de uno a tres meses mientras que la proteinuria puede persistir durante seis meses a un año y la hematuria microscópica puede durar varios años. Con el desarrollo de infecciones respiratorias altas leves puede volver a haber cambios del sedimento urinario.[25]
Los antecedentes de odinofagia, impétigo o infección estreptocócica demostrada por cultivo una a seis semanas antes del comienzo del síndrome y la elevación de los anticuerpos antiestreptocócicos permiten establecer el diagnóstico. Los cilindros de eritrocitos son patognomónicos de cualquier glomerulonefritis pero evaluados en el contexto clínico se consideran muy indicativos de síndrome nefrítico agudo. La ecografía permite distinguir la enfermedad aguda (los riñones suelen ser normales o estar algo agrandados) de la exacerbación de una nefropatía crónica (riñones pequeños).[25]
En síntesis, el diagnóstico de glomerulonefritis aguda posinfecciosa se inicia con el reconocimiento de un síndrome nefrítico agudo en un paciente sin manifestaciones sistémicas previas, lo apoyan el antecedente de una infección (en general por SBHGA) y que curse con hipocomplementemia (C3 y CH50) y se confirma si en una o dos semanas el síndrome comienza a remitir y antes de ocho semanas se normaliza el nivel de C3.[16]
Diagnóstico diferencial
El diagnóstico diferencial de la glomerulonefritis posestreptocócica incluye nefropatía por IgA, glomerulonefritis rápidamente progresiva y glomerulonefritis membranoproliferativa. Es probable que en la glomerulonefritis posestreptocócica la inflamación glomerular sea inducida directamente por una proteína estreptocócica nefritógena y por el depósito mesangial de agregados inmunes con contenido de IgA1 de glicosilación anormal en la nefropatía por IgA.[27]
El diagnóstico diferencial debe incluir:
- Otras causas de glomerulonefritis, a saber, nefropatía por IgA, LES o nefritis por lupus, púrpura de Schönlein-Henoch, síndrome urémico hemolítico, endocarditis bacteriana, crioglobulinemia y síndrome nefrótico.
- Otras causas de edema generalizado, entre ellas, desnutrición, síndrome de malabsorción, afección renal, insuficiencia hepática, insuficiencia cardíaca derecha y angioedema.
- Otras causas de hematuria. Por ejemplo, entre las causas más frecuentes de hematuria macroscópica figuran las infecciones urinarias, los traumatismos, las alteraciones del tracto urinario y, en menor proporción, la litiasis, los trastornos de la coagulación y los tumores. Si la hematuria es microscópica y persistente, las etiologías más comunes son la nefropatía por IgA, el síndrome de Alport, la enfermedad de las membranas basales finas, la hipercalciuria y la compresión de la vena renal izquierda o síndrome de cascanueces.[28] Además, la hematuria puede ser glomerular o extraglomerular y existen varios indicadores para diferenciar una forma de la otra. Antes que nada, cuando la hematuria es glomerular la orina es de color castaño oscuro u ocre o de aspecto similar al de la Coca-Cola y no hay dolor ni síntomas urinarios asociados. La hematuria de origen urológico es de color rojo con cambios durante la micción; por otra parte, puede haber síndrome miccional asociado y coágulos. En cuanto a los estudios de laboratorio, la presencia de acantocitos es patognomónica de la enfermedad glomerular y si existe más de un 5 % la posibilidad es aún más alta. También sugieren un origen glomerular la existencia de eritrocitos dismórficos en un porcentaje superior al 30 % y una proteinuria superior a 100 mg/m². Todos los mencionados son signos de enfermedad glomerular pero su ausencia no la descarta.[28]
Tratamiento
El tratamiento de la glomerulonefritis posestreptocócica es fundamentalmente de sostén porque no existe una terapéutica específica para la enfermedad renal. Cuando la glomerulonefritis aguda se asocie con infecciones crónicas habrá que tratar la infección subyacente.[29]
La evolución es favorable cuando se erradica la infección. Por ende, el tratamiento específico es el destinado a erradicarla pero sin olvidar el tratamiento sintomático y de sostén de las alteraciones asociadas, incluida la diálisis en casos de infección renal aguda o crónica. El tratamiento sintomático incluye antibióticos, reposo, dieta sin sal, diuréticos, antihipertensivos y líquidos administrados en función de la diuresis. Esta última debe ser controlada en forma estricta, al igual que la presión arterial y el peso. La evolución de los niños con esta enfermedad casi siempre es favorable. En ese grupo etario es excepcional la mortalidad en la fase aguda. En cambio, en los pacientes mayores se ha llegado a informar una tasa de mortalidad del veinticinco por ciento en algunas series, sobre todo en casos de glomerulonefritis extracapilar.[30]
El tratamiento, como ya se dijo, es de sostén y se concentra fundamentalmente en las complicaciones por sobrecarga de volumen e insuficiencia renal. Las medidas terapéuticas incluyen restricción de líquidos y de sal, administración de diuréticos y erradicación del proceso infeccioso si permanece activo. En los casos típicos la evolución de largo plazo suele ser favorable. Sin embargo, el síndrome nefrítico agudo requiere ingreso hospitalario y puede cursar con complicaciones graves (edema agudo de pulmón, insuficiencia cardíaca, encefalopatía hipertensiva y necesidad de depuración extrarrenal).[16] Si bien tratar las infecciones con antibióticos antes de que se desarrolle una glomerulonefritis posetreptocócica no parece prevenir ese proceso, si en el momento del diagnóstico existe una infección bacteriana se debe iniciar el tratamiento antibiótico y tratar todas las causas secundarias. Los fármacos inmunosupresores resultan ineficaces y los esteroides pueden agravar el cuadro. Si el paciente desarrolla azoemia y acidosis metabólica se debe restringir la ingesta proteica. La ingesta de sodio solo se reduce cuando hay sobrecarga circulatoria, edema o hipertensión importante; los diuréticos (tiazidas, diuréticos del asa) pueden ayudar a mantener el volumen del líquido extracelular (LEC)[nota 5] expandido. La hipertensión exige tratamiento enérgico. Los casos de insuficiencia renal grave necesitan diálisis.[25]
Algunos autores[8] consideran que lo más importante es restringir la ingesta de sodio y líquidos para evitar complicaciones (insuficiencia cardíaca, insuficiencia renal aguda o encefalopatía hipertensiva). La encefalopatía hipertensiva es la complicación más temida y se manifiesta con cefalea, vómitos, alteraciones de la conciencia, convulsiones, estupor y coma; si hay hipervolemia y mal manejo renal de los líquidos la glomerulonefritis aguda posestreptocócica puede evolucionar a insuficiencia cardíaca y, en contadas ocasiones, a insuficiencia renal.[8]
Los pacientes con presión arterial normal y un volumen urinario de por lo menos 400 mL pueden ser tratados en el domicilio. Cuando la presión arterial es normal el paciente debe guardar reposo relativo mientras que para los pacientes que presenten complicaciones el reposo deberá ser absoluto. Todos los pacientes con hipertensión arterial deben ser internados porque en el veinte por ciento de estos casos hay complicaciones del sistema nervioso central y en otro veinte por ciento se desarrollan alteraciones cardiovasculares potencialmente mortales. Se pueden usar diuréticos del asa como la furosemida para incrementar la diuresis. La hipertensión arterial requiere tratamiento específico en la mitad de los pacientes y se han informado respuestas satisfactorias a la nifedipina administrada por vía intravenosa y a la hidralazina parenteral. La insuficiencia cardíaca también responde al uso de diuréticos. La digital no es efectiva. La encefalopatía hipertensiva se tratará con nitroprusiato de sodio y si no hay respuesta se podrá usar diazóxido. En lo que se refiere a la dieta, durante un mes deberá ser hiposódica y normoproteica.[8]
En todos los familiares cercanos y en los contactos directos y cercanos del paciente se buscará la presencia del estreptococo causal y en los casos con resultados positivos se administrará penicilina G benzatínica en la dosis indicada según el peso y la edad. Los criterios de internación incluirán signos de hipervolemia, hipertensión arterial, insuficiencia renal aguda y riesgo social.[8]
Los pacientes con glomerulonefritis posestreptocócica recibirán antibioticoterapia como si tuvieran una infección activa. Puede usarse una dosis única de 1,2 millones de U de penicilina benzatínica por vía intramuscular o bien por vía oral en la forma de fenoximetilpenicilina por un lapso de diez días. En los pacientes alérgicos a la penicilina esta puede ser sustituida por eritromicina.[8]
Véase también
Notas
- ↑ Es importante mencionar que cada vez hay más casos de glomerulonefritis posinfecciosa con Staphylococcus en lugar de Streptococcus como factor etiológico y varios autores han venido observando que las características morfológicas de la glomerulonefritis posinfecciosa son diferentes de las descritas hace décadas. A este respecto, hace poco se realizó un estudio retrospectivo de 21 casos de la enfermedad atendidos entre julio de 2000 y febrero de 2009 en un centro médico de Taiwán para determinar la importancia de los cambios del espectro clínico-anatomopatológico. Entre los hallazgos informados figura que el agente infeccioso identificado con mayor frecuencia fue Staphylococcus (57,1%) y según la conclusión del autor de este estudio, una de las posibles explicaciones de la morfología atípica puede ser un patrón peculiar de glomerulonefritis posestafilocócica que se ha identificado cada vez con mayor frecuencia en la glomerulonefritis posinfecciosa en los últimos diez años.[17]
- ↑ Por otra parte, en la etiología de la glomerulonefritis posinfecciosa Staphylococcus aureus aparece implicado con mayor frecuencia que Streptococcus betahemolítico del grupo A, al menos en algunos países europeos.[18]
- ↑ Según otros autores, las formas no estreptocócicas son esporádicas.[16]
- ↑ Es importante mencionar que se sabe a ciencia cierta que en los animales y en modelos experimentales los virus pueden causar enfermedades renales por mecanismos patogénicos que abarcan desde una acción citopática directa del virus (como en la glomerulonefritis que se ve en el curso de las infecciones congénitas por citomegalovirus) hasta un mecanismo autoinmune con la formación directa o inducida de inmunocomplejos y el posterior depósito de ese material a distintos niveles del parénquima renal (como sería el caso de la asociación de la infección por el virus de la hepatitis B y la glomerulonefritis membranosa) mientras que en la glomerulonefritis humana la evidencia de etiología viral es indirecta porque aun cuando la asociación temporal pueda proporcionar evidencias muy sugestivas de relación causal entre glomerulonefritis e infección viral aguda (documentada por criterios clínicos, determinación de la carga viral o respuesta serológica), las evidencias de este tipo siguen siendo circunstanciales. Muchos de los virus considerados causales son ubicuos, lo que restaría especificidad a las determinaciones serológicas, y la demostración ultraestructural de partículas virales o similares a virus en los glomérulos o el parénquima en general tampoco debería considerarse evidencia definitiva de etiología viral. Un ejemplo de lo dicho es que si bien la nefritis lúpica no se considera causada directamente por virus, a menudo se observan partículas similares a virus en el estudio ultraestructural o antígenos de oncornavirus a nivel glomerular.[19] Por otro lado, en muestras renales obtenidas de pacientes con lupus o glomerulonefritis por inmunocomplejos idiopática se pueden determinar anticuerpos contra el virus del sarampión o contra el virus de Epstein-Barr junto con títulos séricos elevados de anticuerpos contra los virus mencionados que no significan necesariamente una implicación etiológica. En infecciones por el virus de la varicela, el virus del sarampión, el virus de la parotiditis, el virus de Epstein-Barr y el virus influenza en las que las pruebas serológicas habían descartado una glomerulonefritis posestreptocócica concomitante y los niveles de ASLO eran normales se observaron cuadros de glomerulonefritis proliferativa endocapilar con arteritis asociada o sin ella en los que la evolución era similar a la de las glomerulonefritis agudas clásicas. Otra forma de compromiso glomerular (p. ej., glomerulonefritis focal y segmentaria) se ve en presencia de infecciones por parvovirus B19 en pacientes susceptibles. Se ha comprobado una alta incidencia de serología positiva para Coxackievirus B en niños con síndrome urémico-hemolítico, en los que también se detectó antígeno viral en el parénquima renal por técnica de inmunofluorescencia sin que se pudiera confirmar una implicación etiológica definitiva. En síntesis, pese a que se han descrito diferentes nefropatías en el curso de infecciones virales, es difícil atribuir un papel etiológico directo al virus y diferenciarlo de una mera asociación circunstancial.[20]
- ↑ El líquido extracelular (LEC), que es todo el líquido que no se encuentra dentro de las células y que contiene los nutrientes necesarios para la supervivencia de las que se hallan inmersas en él, representa el treinta y cinco por ciento del agua corporal e incluye gran cantidad de iones sodio (Na+), cloruro y bicarbonato, además de nutrientes celulares como oxígeno, glucosa, ácidos grasos y aminoácidos. También contiene los desechos de las células en proceso de transporte hacia el torrente sanguíneo para su posterior eliminación. El LEC incluye el líquido vascular, el intersticial y el cefalorraquídeo.[31][32]
Referencias
- ↑ a b c d "Reacciones de hipersensibilidad", cap. 15 en Kindt T.J., Goldsby R.A. y Osborne B.A., Inmunología de Kuby, 6a ed., México D.F., McGraw-Hill, 2007, pp. 371-400, ISBN 978-1-4292-0211-4. Disponible para descargar (previo registro) en [1] (enlace roto disponible en Internet Archive; véase el historial, la primera versión y la última).. Consultado el 13 de abril de 2015.
- ↑ a b Baltimore R.S., “Re-evaluation of antibiotic treatment of streptococcal pharyngitis” (Reevaluación del tratamiento antibiótico de la glomerulonefritis posestreptocócica), Curr. Opin. Pediatr. 2010, 22 (1): 77-82. PMID 19996970, doi 10.1097/MOP.0b013e32833502e7. Resumen disponible en [2]. Consultado el 14 de abril de 2015.
- ↑ White A.V., Hoy W.E. y McCredie D.A. “Childhood post-streptococcal glomerulonephritis as a risk factor for chronic renal disease in later life” (Glomerulonefritis posestreptocócica infantil como factor de riesgo de enfermedad renal crónica en el adulto), Med. J. Aust 2001, 174 (10): 492-496. Disponible en [3]. Consultado el 14 de abril de 2015.
- ↑ Plenciz V. y Trattener J.T., Tractatus III de scarlatina, 1792.
- ↑ Bright R., Report of Medical Cases Selected with a View of Illustrating Symptoms and Cure of Disease by Reference to Morbid Anatomy, t. I, Londres, Longman, Rees, Orme, Brown and Green, 1827.
- ↑ Longcope W.T., “The pathogenesis of glomerulonephritis”, Bull Johns Hopkins Hosp 1929; 45: 335-360.
- ↑ Vega Vega O. y Pérez Gutiérrez R.A., “Síndrome nefrítico”, El residente 2008, III (3): 86-89. Disponible en [4]. Consultado el 28 de abril de 2015.
- ↑ a b c d e f Pérez L.B. y Ramos M., “Glomerulonefritis aguda post-estreptocócica: revisión bibliográfica”, Revista de Posgrado de la VIa Cátedra de Medicina, N° 135, febrero de 2004. Disponible en [5] Archivado el 13 de febrero de 2015 en Wayback Machine.. Consultado el 5 de mayo de 2015.
- ↑ Iglesias-Gamarra A., Siachoque H., Pons-Estel B., Restrepo J.F., Quintana L. G. y Gómez A., “Historia de la autoinmunidad. Primera Parte. La inmunología ¿desde dónde y hacia dónde?”, Rev.Colomb.Reumatol., enero-marzo de 2009, vol. 16, No. 1, Bogotá. ISSN de la versión en papel: 0121-8123. Disponible en [6]. Consultado el 13 de mayo de 2015.
- ↑ Rodríguez-Iturbe B. y Batsfor S., “Patogénesis de la glomerulonefritis pos estreptocócica un siglo después de Clemens von Pirquet”, Kidney International 2007, 3: 212-222.
- ↑ Stefanini M., Piomelli S. y Mele R.H., “Immuno-Hematologic Disorders in Childhood”, Int Arch Allergy 1959;15:16-34. doi 10.1159/000229032. ISSN 1018-2438 (edición en papel) e ISSN 1423-0097 (publicación en línea).
- ↑ a b Rammelkamp Ch.H.(Jr). y Weaver R.S., “Acute glomerulonephritis. The significance of the variations in the incidence of the disease”, J. Clin. Invest. 1953, 32:345.
- ↑ Rodríguez B., Parra G., "Glomerulonefritis endocapilar aguda", en Rodríguez B., Parra G.: Nefrología clínica, Ed. Panamericana, Madrid, España, 1997: 271-276.
- ↑ Earle D.P. y Jennings R.B., “Post-streptococcal glomerulonephritis”, en Cyba Foundation Symposium, Renal Biopsy: Clinical and Pathological Significance, Gran Bretaña, 14-16 de marzo de 1961. Vista previa disponible en [7]. Consultado el 13 de mayo de 2012.
- ↑ Barnhan M., Thornton T.J. y Lange K., "Nephritis caused by Streptococcus zooepidemicus (Lancefield Group C)", Lancet 1983; 1:945 948.
- ↑ a b c d e f g h i j k l m n ñ o p Fernández Maseda M.A. y Romero Sala F.J., “Glomerulonefritis aguda postinfecciosa", Protoc diagn ter pediatr. 2014;1:303-314. Disponible en [8]. Consultado el 17 de abril de 2015.
- ↑ Wen Y.K. y Chen M.L., “The significance of atypical morphology in the changes of spectrum of postinfectious glomerulonephritis”, Clin Nephrol. 2010; 73(3):173-9 (ISSN 0301-0430). Division of Nephrology, Department of Internal Medicine, Changhua, Taiwán. wensnake1100@yahoo.com.tw. Resumen disponible en [9]. Consultado el 19 de abril de 2015.
- ↑ ”Glomerulonefritis”, Ecotrópicos, versión electrónica de la Revista venezolana de la Universidad de los Andes. Disponible en [10] (enlace roto disponible en Internet Archive; véase el historial, la primera versión y la última)..Consultado el 18 de abril de 2015.
- ↑ Ronco P., Verroust P., Morel-Maroger L., “Viruses and glomerulonephritis”, Nephron 1982; 31: 97-102. doi 10.1159/000182626.
- ↑ Orellana Fernández R., Almirall Daly1 J., Navarro F.J.A., “Nefropatía asociada a infecciones víricas”, Rev Esp Patol. 2002, 35 (2). Disponible en [11].Consultado el 27 de abril de 2015.
- ↑ En caso de quistes renales el depósito de antígeno hidatídico en los glomérulos puede provocar una glomerulonefritis membranosa. Mendoza Rodríguez D., “Echinococcus spp.”, cap. 115 en Llop Hernández A., Microbiología y Parasitología Médicas, t. III, Sección VI, Parásitos, ECIMED, La Habana, Departamento de Publicaciones Electrónicas, 2001. Consultado el 18 de abril de 2015.
- ↑ a b c Barat A., del Barrio Molina M. y Manzarbeitia F., “Sinopsis de patología ultraestructural del glomérulo renal”, Rev Esp Patol 2002, vol. 35, Nº 2, pp. 151-166. Disponible en [12]. Consultado el 11 de mayo de 2015.
- ↑ Oliva H., Sarasa J.L., Rivas C., Barat A., Renedo G., Rivas F. et al., “Introducción a la microscopia electrónica diagnostica (I)”, JANO. Medicina y Humanidades 1984; 616, pp. 25-93.
- ↑ Sung H.Y., Lim C.H., Shin M.J. et al., “A case of post-streptococcal glomerulonephritis with diffuse alveolar hemorrhage” (Un caso de glomerulonefritis posestreptocócica con hemorragia alveolar difusa), J. Korean Med. Sci. 2007, 22 (6):1074-1078. PMID 18162726, doi 10.3346/jkms.2007.22.6.1074 10.3346/jkms.2007.22.6.1074. Disponible (resumen) en [13]. Consultado el 13 de abril de 2015.
- ↑ a b c d e f Manual Merck, “Enfermedades glomerulares (glomerulopatías)”, cap. 224, «Diversos procesos patológicos que afectan fundamentalmente al glomérulo e incluyen a las glomerulonefritis, aunque no se limitan a ellas». Disponible en [14]. Consultado el 3 de mayo de 2015.
- ↑ Examen microscópico del sedimento urinario. Métodos para su análisis.
- ↑ Couser W.G., “Glomerulonephritis”, The Lancet 353 (9163):1509-1515. doi 10.1016/S0140-6736(98)06195-9. Resumen disponible en [15]. Consultado el 14 de abril de 2015.
- ↑ a b Tauler Girona M.C., “Hematuria, proteinuria: actitud diagnóstica”, Pediatr Integral 2013; XVII (6): 412-421. Disponible en [16]. Consultado el 28 de abril de 2015.
- ↑ Parmar, M.S., “Acute glomerulonephritis” (publicado en línea el 12 de diciembre de 2014). Disponible en [17]. Consultado el 2 de mayo de 2015.
- ↑ Gómez Campderá F., “Afección renal en las enfermedades infecciosas”, JANO, febrero-marzo de 2004, vol. LXVI, Nº 1.509, pp. 45-50. Disponible en [18] (enlace roto disponible en Internet Archive; véase el historial, la primera versión y la última).. Consultado el 2 de mayo de 2015.
- ↑ Diccionario médico disponible en Médicos cubanos.com.[19].
- ↑ Diccionario de Fisiología.
Enlaces externos
Wikimedia Commons alberga una categoría multimedia sobre Nefrología.
Wikcionario tiene definiciones y otra información sobre glomerulonefritis.
Wikispecies tiene un artículo sobre Streptococcus.
Wikiversidad alberga proyectos de aprendizaje sobre nefrología.- Glomerulonefritis posestreptocócica - Mayo Clinic
- Infecciones por estreptococos del grupo A - National Institute of Allergy and Infectious Diseases
